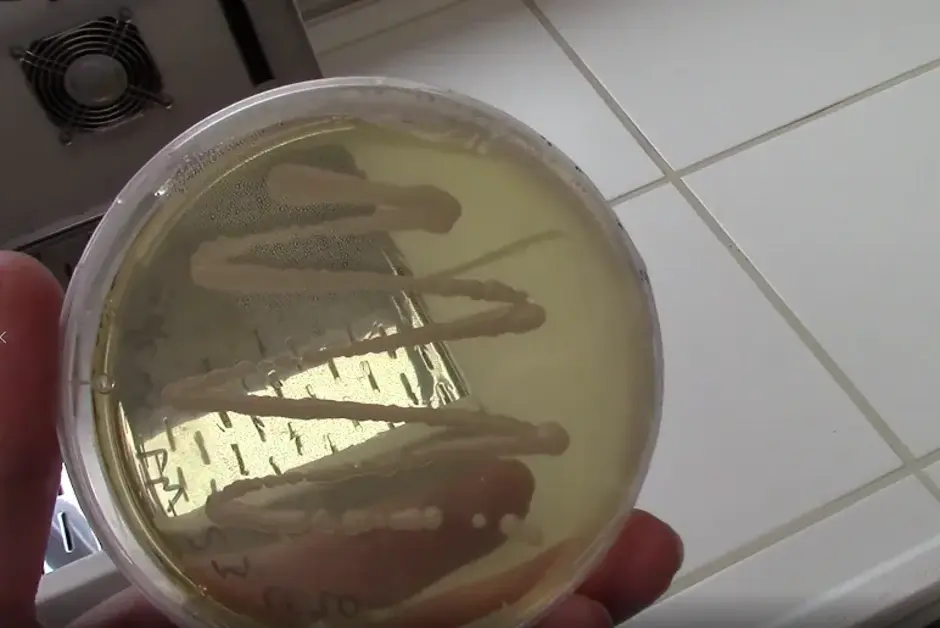

Studiengangvorstellung "Erneuerbare Energien (B.Sc.)"
Konzept und der Inhalt des Bachelorstudiengangs "Erneuerbare Energien"

Bitte beachten Sie: Sobald Sie sich das Video ansehen, werden Informationen darüber an Youtube/Google übermittelt. Weitere Informationen dazu finden Sie unter Google Privacy.
Robotix Academy @ LebensWert Arbeit
Die Robotix-Akademie war im letzten Jahr bei den Karl-Marx-Wochen in Trier vertreten.

Bitte beachten Sie: Sobald Sie sich das Video ansehen, werden Informationen darüber an Youtube/Google übermittelt. Weitere Informationen dazu finden Sie unter Google Privacy.
Selbstfahrender Hauspost Demonstrator mit Bestellsystem
Das Video demonstriert einen Abhol- und Auslieferungsvorgang der selbstfahrenden Hauspost am Umwelt Campus (Prototyp).

Bitte beachten Sie: Sobald Sie sich das Video ansehen, werden Informationen darüber an Youtube/Google übermittelt. Weitere Informationen dazu finden Sie unter Google Privacy.
Mensch-Roboter Kollaboration bei der Demontage
Testaufbau zur Demontage von Getriebemotoren im Technikum des Umwelt-Campus

Bitte beachten Sie: Sobald Sie sich das Video ansehen, werden Informationen darüber an Youtube/Google übermittelt. Weitere Informationen dazu finden Sie unter Google Privacy.
Schnuppervorlesung "Bewegungssimulation eines Gabelstaplers"
Im Masterstudiengang Digitale Produktentwicklung lernen die Studierenden den Umgang mit digitalen Simulationsmodellen.

Bitte beachten Sie: Sobald Sie sich das Video ansehen, werden Informationen darüber an Youtube/Google übermittelt. Weitere Informationen dazu finden Sie unter Google Privacy.
Schnuppervorlesung "Diesel - Benziner" von Prof. Dr. Gregor Hoogers

Bitte beachten Sie: Sobald Sie sich das Video ansehen, werden Informationen darüber an Youtube/Google übermittelt. Weitere Informationen dazu finden Sie unter Google Privacy.
Studiengangvorstellung "Medieninformatik (B.Sc.)"
Konzept und der Inhalt des Bachelorstudiengangs "Medieninformatik"

Bitte beachten Sie: Sobald Sie sich das Video ansehen, werden Informationen darüber an Youtube/Google übermittelt. Weitere Informationen dazu finden Sie unter Google Privacy.
COSY-Trailer
IoT - KI - Forschung - Nachhaltigkeit

Bitte beachten Sie: Sobald Sie sich das Video ansehen, werden Informationen darüber an Youtube/Google übermittelt. Weitere Informationen dazu finden Sie unter Google Privacy.
Die Schallortung
Nicht ganz ernst gemeintes Video zur Umsetzung einer Ortungstechnologie auf Basis von KI-Algorithmen und IoT-Werkzeugen zur Auswertung von Schallwellen.

Bitte beachten Sie: Sobald Sie sich das Video ansehen, werden Informationen darüber an Youtube/Google übermittelt. Weitere Informationen dazu finden Sie unter Google Privacy.
Visuelle und akustische Impressionen des Nationalpark Hunsrück Hochwald
Projektarbeit für das Wahlpflichtfach Crossmedia

Bitte beachten Sie: Sobald Sie sich das Video ansehen, werden Informationen darüber an Youtube/Google übermittelt. Weitere Informationen dazu finden Sie unter Google Privacy.
Steuerung eines Roboter mittels Sprachassistent
Robotix Academy Alexa Skill

Bitte beachten Sie: Sobald Sie sich das Video ansehen, werden Informationen darüber an Youtube/Google übermittelt. Weitere Informationen dazu finden Sie unter Google Privacy.
Fachrichtung Maschinenbau
Virtueller Rundgang durch die Labore der Fachrichtung Maschinenbau
Geoinformatik am Umwelt-Campus Birkenfeld
Imagefilm der Geoinformatik am Umwelt-Campus Birkenfeld, die ein Kerninhalt des Bachelor-Studiengangs Umwelt- und Wirtschaftsinformatik ist.

Bitte beachten Sie: Sobald Sie sich das Video ansehen, werden Informationen darüber an Youtube/Google übermittelt. Weitere Informationen dazu finden Sie unter Google Privacy.
Die künstliche Nase
Erklärung der Konzepte zur Umsetzung einer künstlichen Nase. KI-Algorithmen und IoT-Werkzeuge leicht verständlich in einem kurzen Video erklärt.

Bitte beachten Sie: Sobald Sie sich das Video ansehen, werden Informationen darüber an Youtube/Google übermittelt. Weitere Informationen dazu finden Sie unter Google Privacy.
Akustische Ökologie im Nationalpark Hunsrück Hochwald
Im Nationalpark erforscht das Crossmedia-Team mithilfe moderner Technik die Geräusche des Waldes.

Bitte beachten Sie: Sobald Sie sich das Video ansehen, werden Informationen darüber an Youtube/Google übermittelt. Weitere Informationen dazu finden Sie unter Google Privacy.
Rundgang durch das Biologie-Labor
Ein Studierender des Studiengangs Bio- und Pharmatechnik führt durch das Labor. Es werden verschiedene Arbeitsplätze mit deren Geräten von der Sterilwerkbank bis Fermenter gezeigt und einige im Labor gängige Arbeitstechniken erklärt.
Bitte beachten Sie: Sobald Sie sich das Video ansehen, werden Informationen darüber an Youtube/Google übermittelt. Weitere Informationen dazu finden Sie unter Google Privacy.
Sie verlassen die offizielle Website der Hochschule Trier